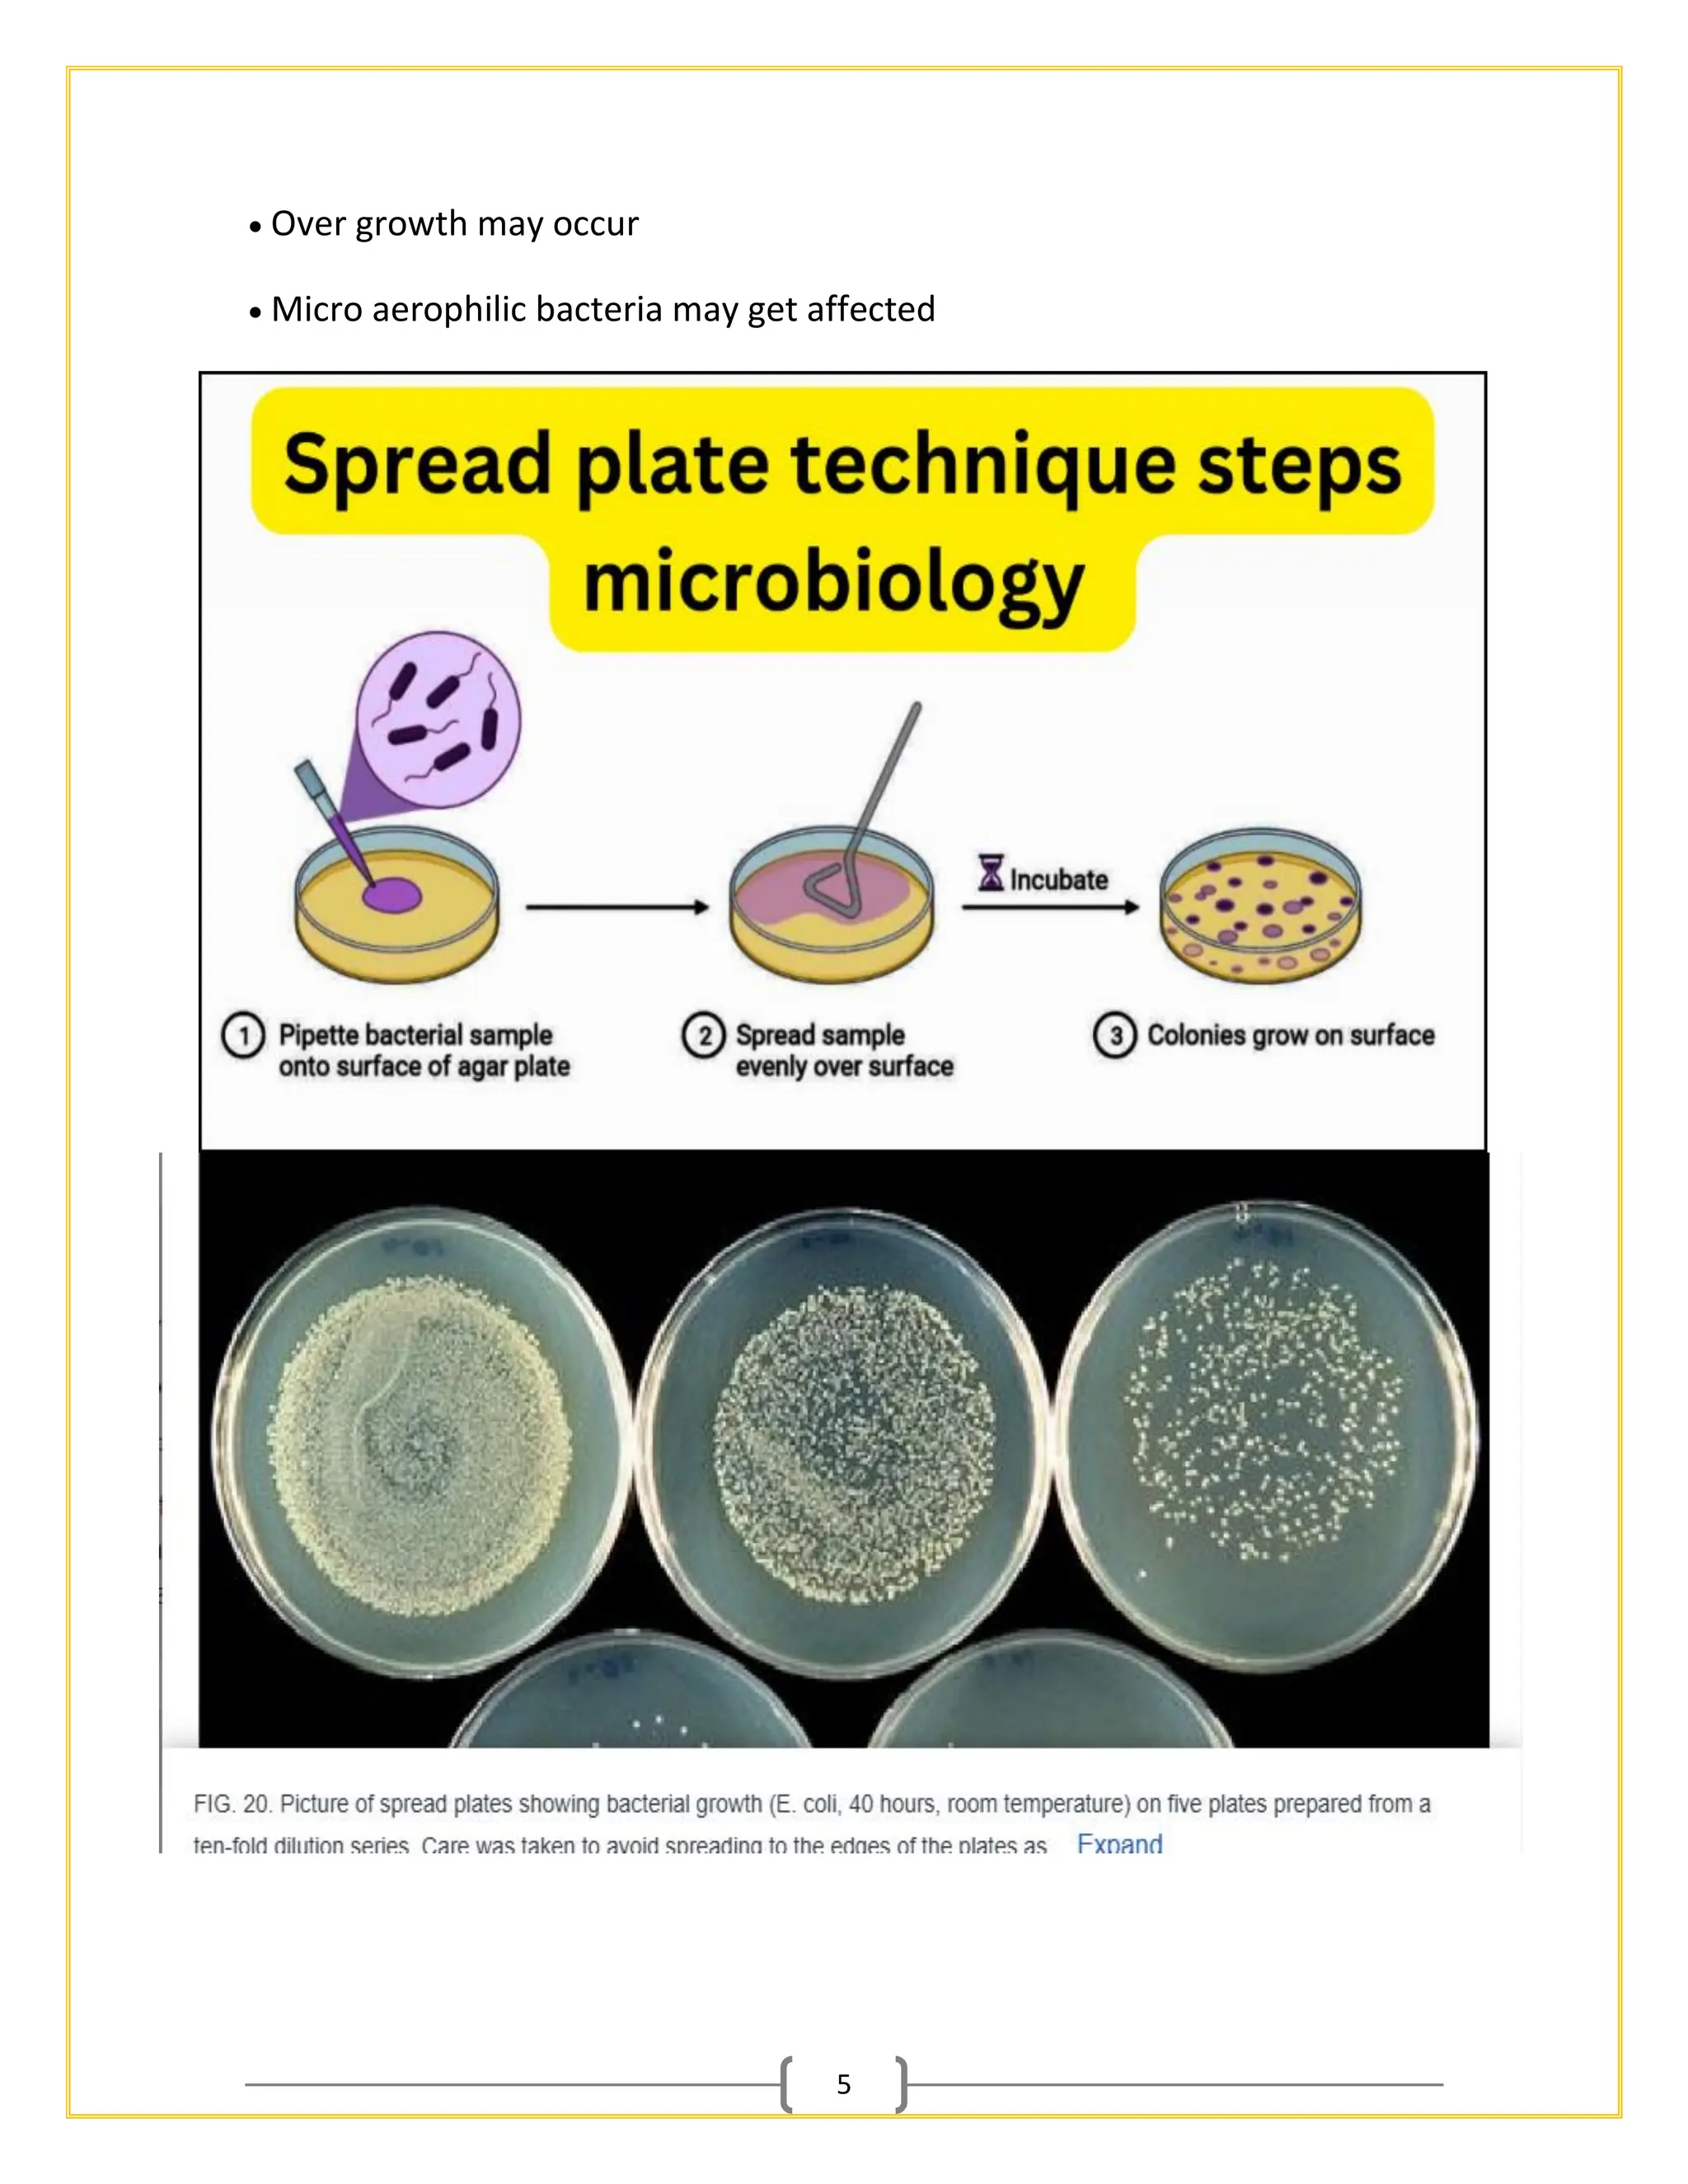
5
• Over growth may occur
• Micro aerophilic bacteria may get affected
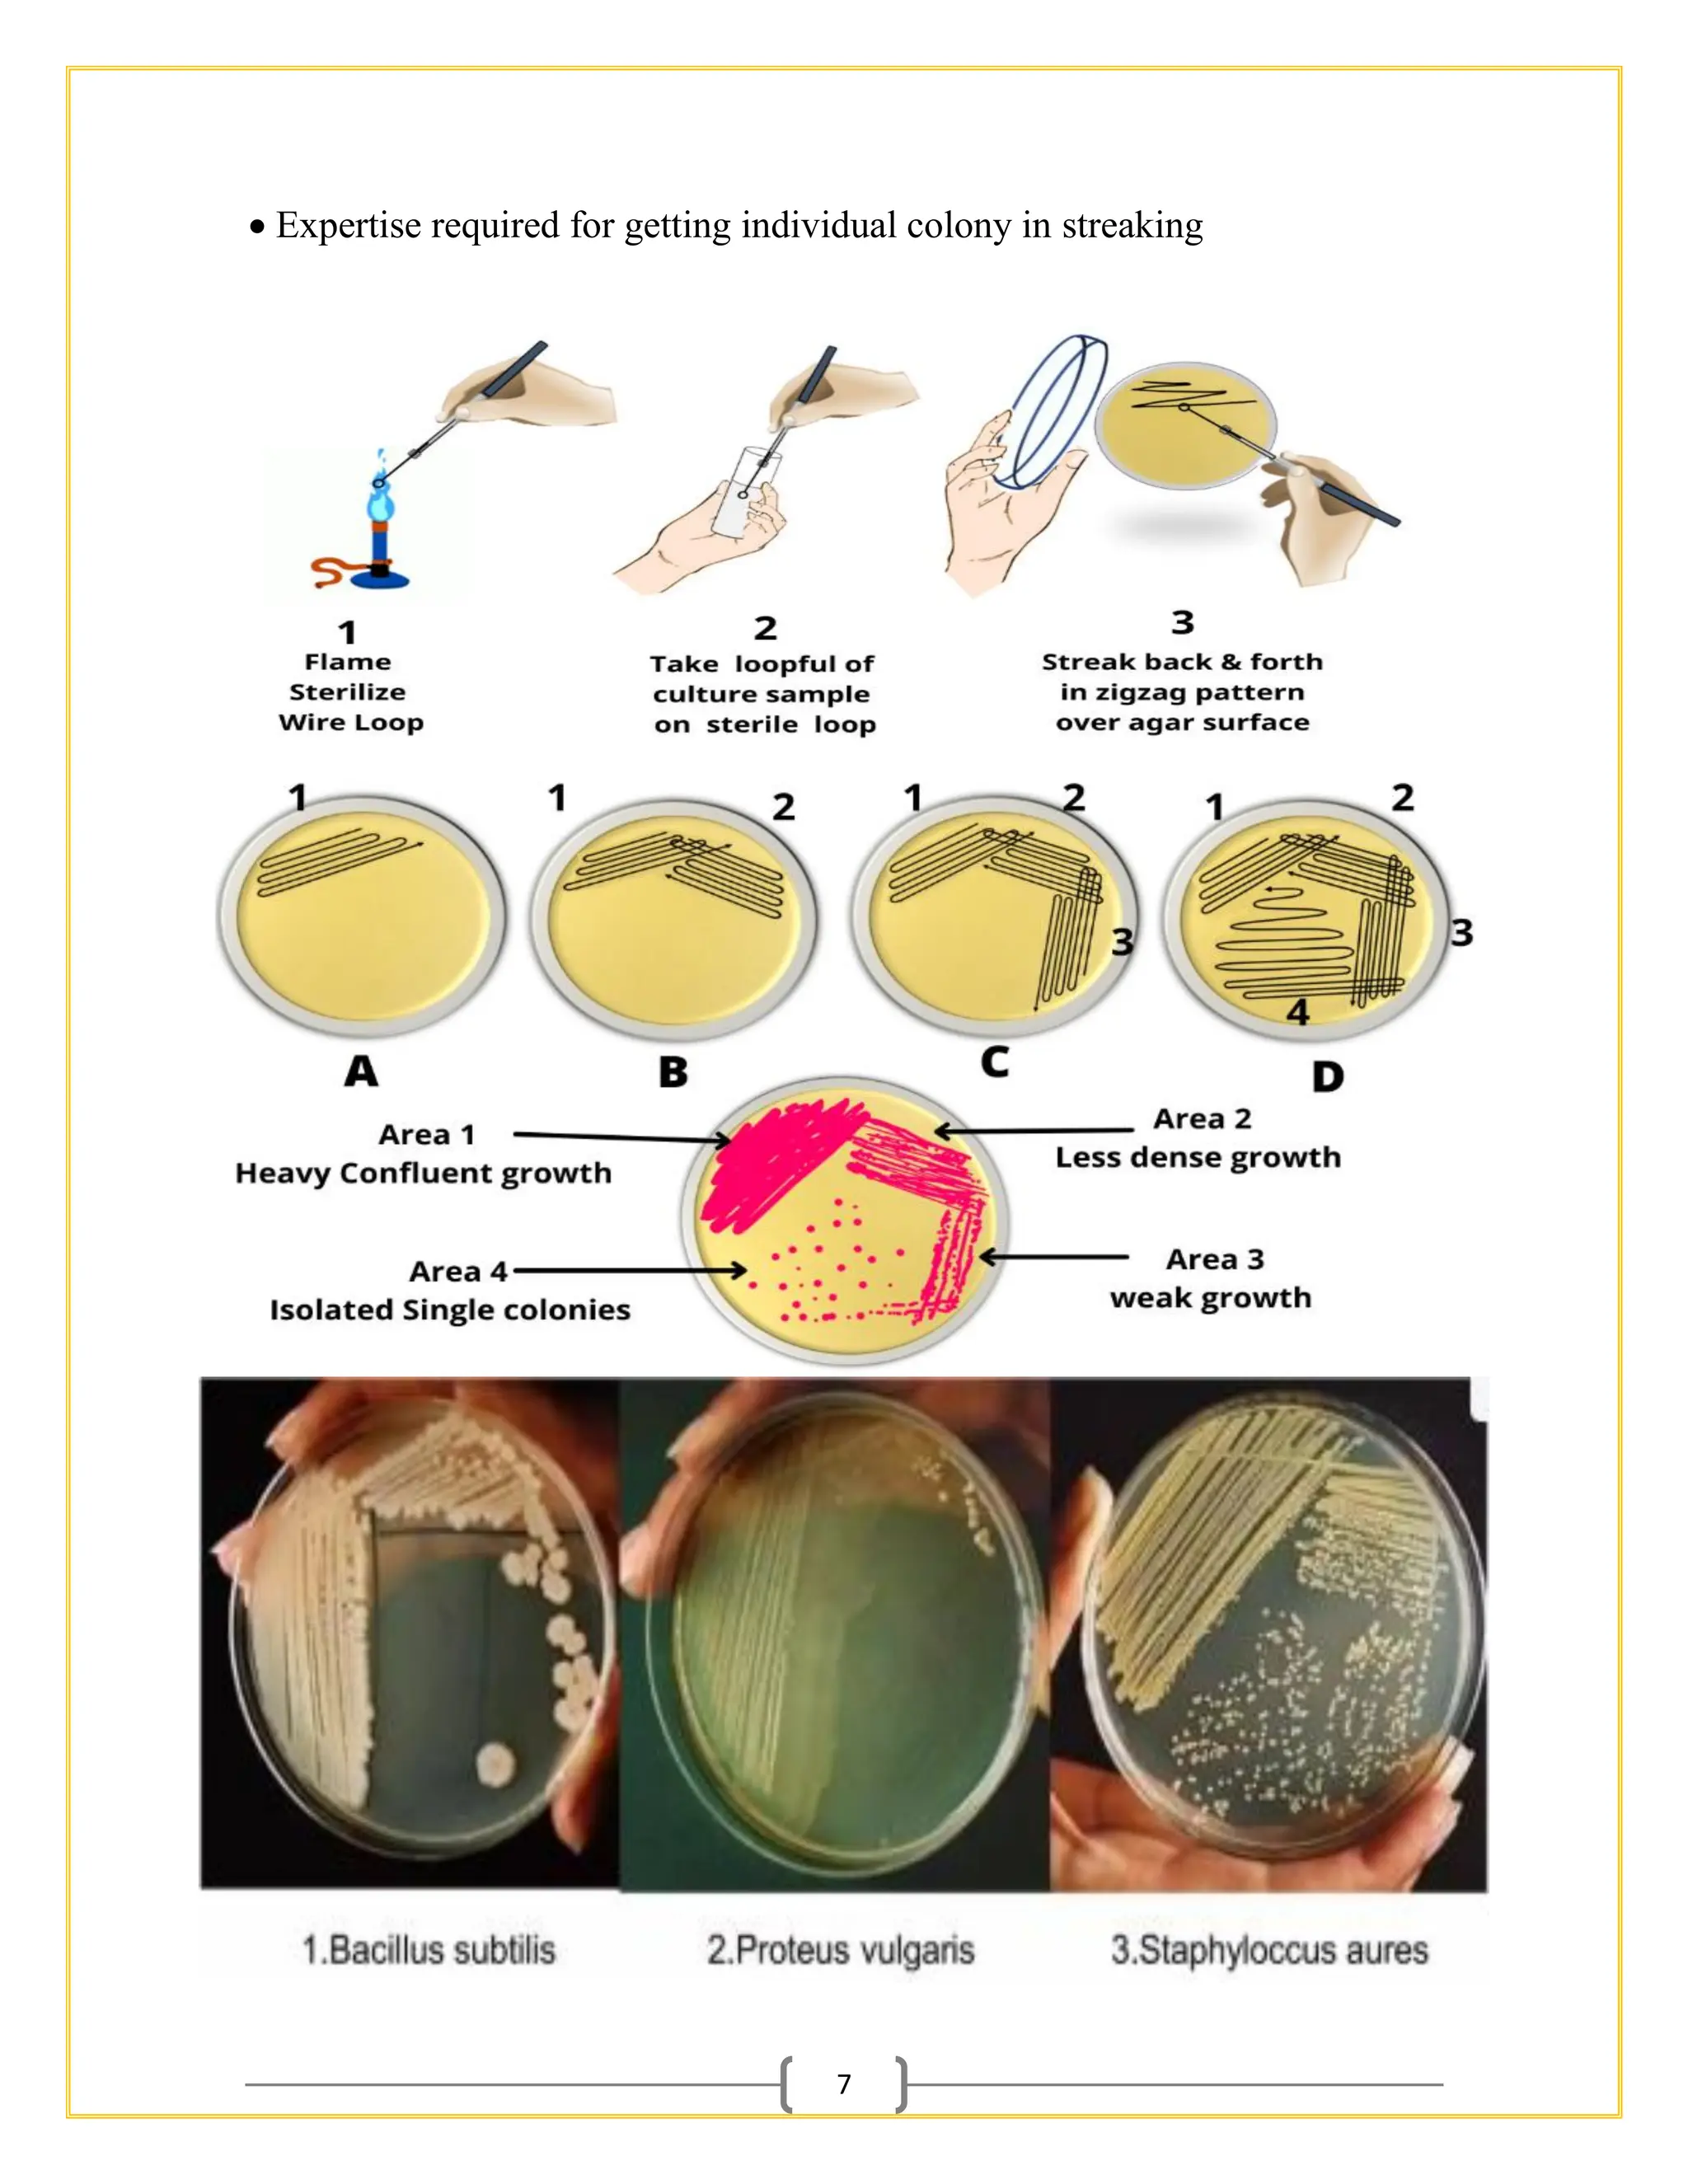
7
• Expertise required for getting individual colony in streaking

The document outlines essential procedures and safety protocols for performing microbiological studies, focusing on methods such as pour plate, spread plate, and streaking techniques for isolating and identifying bacteria. Each method is described with its advantages, limitations, and specific steps to ensure accuracy and minimize contamination. Additionally, it includes guidance on antibiotic sensitivity testing using plating methods to evaluate bacterial responses to antibiotics.